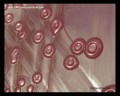
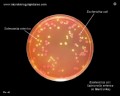
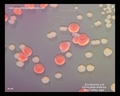
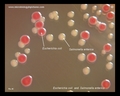
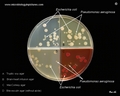

Escherichia coli


Four different strains of Escherichia coli on Endo agar with biochemical slope (see here). Glucose fermentation with gas production, urea and H2S negative, lactose positive (with exception of strain D - "late lactose fermenter"; on Endo agar it looks like lactose negative). All four strains are mannitol positive (best seen in fig. D), cellobiose negative (strains A, B). Approximately 50% of E.coli strains are sucrose negative (fig.A, D). Colonies of some strains have typical greenish metallic sheen (fig.E) but many of them grow without it (fig.F).
Escherichia coli (commonly abbreviated E. coli) is a Gram-negative, rod-shaped bacterium that is commonly found in the lower intestine of warm-blooded organisms (endotherms). Most E. coli strains are harmless, but some serotypes can cause serious food poisoning in humans. The harmless strains are part of the normal flora of the gut, and can benefit their hosts by producing vitamin K2, and by preventing the establishment of pathogenic bacteria within the intestine. E. coli and related bacteria constitute about 0.1% of gut flora, and fecal-oral transmission is the major route through which pathogenic strains of the bacterium cause disease.
Gastrointestinal infection
Certain strains of E. coli, such as O157:H7, O104:H4, O121, O26, O103, O111, O145, and O104:H21, produce potentially lethal toxins. Food poisoning caused by E. coli can result from eating unwashed vegetables or undercooked meat. O157:H7 is also notorious
for causing serious and even life-threatening complications such as hemolytic-uremic syndrome. The O104:H4 strain is equally virulent. It is the strain behind the deadly June 2011 E. coli outbreak in Europe.
Enteric E. coli (EC) are classified on the basis of serological characteristics and virulence properties:
- Enterotoxigenic E. coli (ETEC)
- Enteropathogenic E. coli (EPEC)
- Enteroinvasive E. coli (EIEC)
- Enterohemorrhagic E. coli (EHEC)
- Enteroaggregative E. coli (EAEC)
Escherichia coli and Urinary Tract Infections (UTIs)
Escherichia coli and urinary tract infections are often discussed together as E. coli (uropathogenic E. coli, UPEC) is often indicated as the major cause of UTIs. Basically, the urinary tract comprises the parts of the body responsible for the removal of body waste and excess water, and the maintenance of electrolyte balance in the body. The urinary tract includes the kidneys, the bladder, the urethra and the ureters.Causes of UTIs
Naturally, the urinary system is immune to infections; therefore, certain microorganisms must invade it before it can be infected. In ascending infections, fecal bacteria colonize the urethra and spread up the urinary tract to the bladder as well as to the kidneys (causing pyelonephritis), or the prostate in males. Because women have a shorter urethra than men, they are more likely to suffer from an ascending UTI. Escherichia coli are the main causative bacteria of UTIs; they are responsible for 4 out of 5 cases of the infections. Uropathogenic E. coli use P fimbriae (pyelonephritis-associated pili) to bind urinary tract endothelial cells and colonize the bladder. Uropathogenic E. coli often produce alpha- and beta-hemolysins, which cause lysis of urinary tract cells.Apart from E. coli, other bacteria like Pseudomonas aeruginosa, Staphylococcus saprophyticus, Neisseria gonorrhoeae, Klebsiella pneumoniae, Enterococcus faecalis, Proteus spp. are also capable of causing urinary tract infections. The most common yeasts causing complicated and uncomplicated urinary tract infections are Candida albicans and other Candida species (e.g., C.glabrata). Rarely they may be due to viral or parasitic infections.
Symptoms of UTIs
In some cases, urinary tract infections and other Escherichia coli infections are often unnoticed as they show no symptoms. However, their common symptoms include:- Burning sensations during urination
- Feverish conditions
- Constant, strong urge to urinate
- In male – pain in the rectal region
- In female – pain in the pelvis
- Frequency, intense passing out of small amounts of urine
- Urine with appearances of blood and/or foul odor
- Pain around the hips, abdomen, or lower back region
Complications
There are rarely any major complications associated with urinary tract infections. However, if the infections are left untreated for long, chronic infections may develop with conditions such as kidney stone, abscesses, fistulas and, in some rare cases, cancer of the bladder, kidney damages or death.Treatment of Urinary Tract Infections
The infections are generally treated with the aid of antibiotics which are substances capable of destroying bacteria and other related organisms in the body. Antibiotics can either be given orally (e.g., nitrofurantoin) or intravenously based on the severity of the infections. They are given orally if the infections are still at their mild state, while they would be given via the vein (intravenous mode) in severe cases.Preventions of Urinary Tract Infections
Urinary tract infections can be prevented through:CDC.
Neonatal meningitis
It is produced by a serotype of Escherichia coli that contains a capsular antigen called K1. The colonisation of the newborn's intestines with these strains, that are present in the mother's vagina, lead to bacteraemia, which leads to meningitis. And because of the absence of the IgM antibodies from the mother (these do not cross the placenta because FcRn only mediates the transfer of IgG), plus the fact that the body recognises as self the K1 antigen, as it resembles the cerebral glicopeptides, this leads to a severe meningitis in the neonates.Escherichia coli basic characteristics
- GRAM-NEGATIVE RODS
- MOTILE
- NON-SPORE-FORMING
- CATALASE: POSITIVE
- OXIDASE: NEGATIVE
- FACULTATIVELY ANAEROBIC
Escherichia coli biochemical identification
MacConkey growth |
Indole production |
Methyl red |
Voges- Proskauer |
Citrate (Simmons) |
Hydrogen sulfide(TSI) |
Urea hydrol. |
Lysine decarb. |
Arginine dihydrol. |
Ornithine decarb. |
POS. | POS. | POS. | NEG. | NEG. | NEG. | NEG. | POS. | d | D |
Motility (36 °C) |
D-glucose acid/gas |
D-mannitol ferm. |
Sucrose ferm. |
Lactose ferm. |
D-sorbitol ferm. |
Cellobiose | Esculin hydrol. |
Acetate utiliz. |
ONPG test |
POS. | POS./POS. | POS. | D | POS. | POS. | NEG. | NEG. | D | POS. |
- POS. positive ( > 90% of strains are positive)
- D most positive (51 - 89%)
- d most negative (11 - 50%)
- NEG. negative (0 - 10%)
- Cephalosporins I, II, III (e.g., ceftriaxone)
- Ampicillin
- Aminoglycosides
- Trimethoprim-sulfamethoxazole
- Doxycycline
- Nitrofurantoin
- Quinolones (e.g., norfloxacin, ofloxacin, ciprofloxacin)
- Imipenem
- Meropenem
- AMP + GEN
- List of antibiotics (Wikipedia)
Antibiotic treatment of Escherichia coli infections
IF SUSCEPTIBLE:
ALTERNATIVES:
Escherichia coli colonies on agar cultivation media
E.coli on blood agar










E.coli on MacConkey

E.coli on Endo agar












E.coli on CLED agar





Other solid cultivation media for microbiology

E.coli sensitivity to antibiotics


Escherichia coli identification








E.coli Gram-stain

E.coli SEM


E.coli 3D


Useful Links
WIKIPEDIACENTERS FOR DISEASE CONTROL AND PREVENTION (CDC)
Todar's Online Textbook of Bacteriology
Microbe Wiki (the student-edited microbiology resource)
www.antimicrobe.org
www.vetbact.org
Merck Manuals